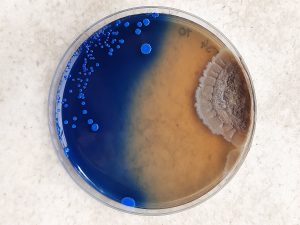

Infoabende
Du möchtest alles über die Chemieschule und unsere Ausbildungen erfahren? Wir bieten dir jeden ersten Mittwoch im Monat die Gelegenheit dazu!
In einem kurzen Vortrag stellen wir dir alle wichtigen Informationen vor und stehen dir für alle deine Fragen zur Verfügung. Anschließend zeigen wir in einer kurzen Führung durch die Schule ausgewählte (Labor-) Räume.
Wir freuen uns auf dein Kommen!
Nächste Termine
6. Mai 2026, 19:00 Uhr
3. Juni 2026, 19:00 Uhr
1. Juli 2026, 19:00 Uhr
Bitte melde dich vorher telefonisch an, gerne auch kurzfristig!
Tag der offenen Tür
Besichtige unsere Labore und tausche dich mit unseren Schülern/innen und Lehrern/innen aus.
Wir freuen uns darauf, dich kennenzulernen und dir unsere Schule vorzustellen!
nächster Termin
Mittwoch, 18.11.2026
(Buß- und Bettag)
9:00 - 13:00 Uhr
Schulführungen
jeden Donnerstag um 14:00 Uhr (nicht in den Schulferien)
Jeden Donnerstag kannst Du während des Unterrichts einen Blick in unsere Labore werfen und Einblicke in den Praktikumsbetrieb gewinnen. Dabei stehen wir dir für alle Fragen zur Verfügung.
Wir freuen uns darauf, dir unsere Schule zu zeigen!
Entdecke die Chemieschule hautnah!
Bitte melde dich vorher telefonisch an, gerne auch kurzfristig!
Schnuppertage
an ausgewählten Samstagen von 9 – 12 Uhr
Erlebe die Faszination im Labor hautnah!
Wenn du schon immer einmal selbst spannende Experimente durchführen und die verschiedenen Bereiche der Biologie und der Chemie entdecken wolltest, dann sind unsere Schnuppertage genau das Richtige für dich.
Hier hast du die Chance, Laborluft zu schnuppern und einfache, aber faszinierende Experimente selbst auszuprobieren.
Mach mit und finde heraus, wie viel Spass praktisches Arbeiten im Labor macht!
Damit wir dich optimal betreuen können, ist die Teilnehmerzahl begrenzt. Melde dich bitte per E-Mail an.
Wir freuen uns darauf, dich bei uns begrüßen zu dürfen!
Übersicht
Unsere neuen Schnuppertage starten im Januar 2026. Folgende Themen bieten wir dieses Schuljahr an:
Untersuchung der Inhaltsstoffe von Orangenöl und Orangensaft
Orangen werden bei uns auch als Apfelsinen (Äpfel aus China) bezeichnet. Sie gehören zur Gattung der Citrusfrüchte. Das Fruchtfleisch und der Saft haben als wichtige Vitaminspender schon lange einen festen Platz in unserer Ernährung.
Orangenöl wird als Aromastoff beim Backen eingesetzt und ist darüber hinaus ein vielseitig verwendbares Lösungsmittel. Der Ölgehalt der Schalen liegt etwa bei einem halben Prozent. Aus einer Tonne Orangenschalen lassen sich folglich nur einige Kilogramm Öl gewinnen. In Anbetracht der großen Mengen an Citrusfrüchten, die zur Saftherstellung dienen, ergibt sich hier jedoch ein erhebliches Rohstoffpotential.
Die etherischen Öle in der Schale schützen die Orangen vor Insekten, Pilzen und Bakterien. Diese desinfizierende Wirkung zusammen mit den fettlösenden Eigenschaften machen das Öl zu einem angenehm duftenden Reinigungsmittel im Sanitärbereich.
Im Rahmen des Schnuppertages bestimmen wir den Gehalt an Vitamin C von Orangensäften.
- Wir trennen die Bestandteile des Orangenöles durch Dünnschichtchromatographie und identifizieren den Hauptbestandteil (+)-Limonen.
- Wir testen Orangenöl als Lösungsmittel an unterschiedlichen Stoffen.
Macht das dick?
Fett ist ein wesentlicher und oft auch wertbestimmender Bestandteil von vielen Lebensmitteln. Besonders die versteckten, „unsichtbaren“ Fette konsumieren wir oft unbewusst in erheblichen Mengen.
Am Schnuppertag werden wir den Fettanteil von Kakaopulver durch kontinuierliche Extraktion herauslösen und seine Menge bestimmen.
Ist das ein saurer oder ein trockener Wein?
Je nach Reife, Klima (Sonne) und Rebsorte enthalten Weintrauben unterschiedliche Mengen an Zucker und Fruchtsäuren. Während die Zucker durch die Gärhefe ganz oder teilweise in Alkohol umgewandelt werden, bleiben die Säuren weitgehend erhalten.
In Rotwein ist eine Säurebestimmung mit einem Indikatorfarbstoff nicht möglich, deshalb wird die Konzentration der Säuren mit Hilfe einer „pH-Elektrode“ bestimmt. Der Gehalt an Zucker lässt sich einfach mit Kupfersalzlösungen abschätzen.
Muntermacher Milch
Die Werbung lobt oft die Vorteile von Milch als Getränk. Untersuchen wir verschiedene Bestandteile, von Enzymen bis zur Lactose.
Wie kommt der Geist in die Flasche?
Lebende Hefezellen, die sich durch die Flaschengärung noch im Weißbier befinden, sorgen für den „Geist“ des Getränks. Diese Zellen werden wir unter dem Mikroskop direkt und nach Anfärbung beobachten.
Wie süß ist Coca Cola?
Zucker können, da sie unsymmetrisch gebaute Moleküle besitzen, polarisiertes Licht „drehen“. Wir wollen den Drehwinkel von Zuckerlösungen messen und so auf den Zuckergehalt schließen.
Wasser
- bedeckt 70% der Erdoberfläche
- ist die Grundlage für das Leben auf unserem Planeten.
- ist der wichtigste Baustein aller lebenden Organismen.
- ist ein Hauptbestandteil aller lebenden Organismen
- löst Salze und kann damit unserem Körper Mineralstoffe und Spurenelemente zuführen
- ist das grundlegende Lebensmittel.
An unserem Schnuppertag testen wir den Geschmack von verschiedenen Mineralwässern und werden feststellen, dass Wasser nicht gleich Wasser ist. Verantwortlich dafür sind die im Wasser gelösten Stoffe, die wir näher untersuchen wollen. Nach der Abtrennung der Salze weisen wir einige Bestandteile chemisch nach und finden heraus welche Stoffe für den unterschiedlichen Geschmack verantwortlich sind. Außerdem messen wir den pH-Wert, der darüber Auskunft gibt, wie viel Kohlendioxid im Wasser gelöst ist. Die Kohlensäure ist dafür verantwortlich, ob das Wasser erfrischend (sauer) oder abgestanden (weniger sauer) schmeckt.
Färbe die in Lebensmitteln verwendeten Bakterien und Pilze, die in der Biotechnologie bei der Lebensmittelherstellung eingesetzt werden und betrachte diese im Mikroskop.
Präpariere Pflanzenzellen einer Küchenzwiebel und mikroskopiere die Zellen mit ihrem gut sichtbaren Zellkern im Inneren.
Verfolge schwimmende Pantoffeltierchen und andere „Tierchen“ in einem Wassertropfen und beobachte diese beim Fressen.
An unserem Schnuppertag färben wir diverse Mikroorganismen und Pflanzenzellen.
Dabei führen wir folgende Versuche durch:
- Methylenblaufärbung und Mikroskopieren von Mikroorganismen aus Lebensmitteln (Pilzen, Bakterien)
- GRAM-Färbung von Bakterienzellen
- Präparation und Färbung eines Querschnitts durch den Stängel von Mais (Astrablau und Safranin-Färbung)
BIOMOLEKÜLE – UNSICHTBARES SICHTBAR MACHEN
Isoliere deine eigene Mundschleimhaut DNA und verschiedene Pflanzenfarbstoffe
Die Grundlage allen Lebens ist die Weitergabe der Erbinformation. Diese ist in Form der so genannten DNA gespeichert. Die auf der DNA lokalisierten Gene bestimmen auch zum größten Teil, wie ein Lebewesen aussieht.
Hättest du geglaubt, dass menschliche und bakterielle DNA gleich aussehen? Aber wo ist dann der Unterschied?
An unserem Schnuppertag werden wir alle diese Fragen beantworten und die DNA aus deiner Mundschleimhaut isolieren. Anschließend trennen wir verschiedene DNA-Moleküle auf einem Agarosegel auf und fotografieren diese.
Zum Abschluss werden wir Pflanzenfarbstoffe aus einigen Grünpflanzen isolieren und die einzelnen Farbstoffe auftrennen. Du wirst staunen, welche Farben alle in grünen Pflanzen zu finden sind.
Warum sind Farbstoffe überhaupt farbig?
Die Farbstoffmoleküle absorbieren aus dem weißen Tageslicht bestimmte Anteile und strahlen den Rest zurück. Wird z.B. Licht der Wellenlänge 480-500 nm absorbiert, erscheint der Farbstoff orangerot; bei Absorption von Licht der Wellenlänge750-800 nm kommt grün als Farbeindruck heraus.
Farbstoffe müssen aber nicht nur farbig sein, für Textilfarben sind weitere Kriterien wichtig: Lichtechtheit, Säure-, Laugen-, Waschechtheit, usw.
An unserem Schnuppertag wollen wir einen Farbstoff herstellen und Stoffstücke damit färben.
Als Bioindikatoren bezeichnet man Lebewesen (Pflanzen oder Tiere), die ein charakteristisches Verhalten bei Einwirkung bestimmter Schadstoffe zeigen.
Ein Bioindikator für Luftverunreinigungen sind Flechten: man findet sie z.B. als gelbgrüne oder gelbe Beläge auf Baumrinden. Einige Flechtenarten sind sehr empfindlich gegenüber erhöhten Schwefeldioxidkonzentrationen in der Luft: ihr Gehalt an Blattgrün (Chlorophyll) sinkt bei steigender Schwefeldioxid-Belastung; sie können schließlich nicht mehr überleben.
An unserem Schnuppertag werden wir uns Flechtenproben holen, die Blattfarbstoffe isolieren, trennen und den Chlorophyllgehalt bestimmen. Hierbei können die Teilnehmer typische Laborverfahren im Bereich Umweltanalytik kennenlernen.
Tipp:
Die Plätze sind für jeden Schnuppertag begrenzt! Sei schnell, wenn du dabei sein willst!
Weitere Termine
Stereoskopie Treffen
Die Regionalgruppe München der Deutschen Gesellschaft für Stereoskopie (DGS) trifft sich einmal pro Monat (außer August) an festgelegten Tagen ab 18 Uhr im Raum 124 in der Chemieschule Dr. Erwin Elhardt.
In diesem Jahr gibt es die folgenden Termine (jeweils Mittwoch):
- 6. Mai 2026
- 3. Juni 2026
- 1. Juli 2026
- 2. September 2026
- 7. Oktober 2026
- 4. November 2026
- 2. Dezember 2026
Alle Stereobegeisterten oder Stereointeressierten sind zum monatlichen Treffen eingeladen. Bringen Sie Ihre Stereodias und Stereobilder mit oder Ihre Probleme bei der Realisierung Ihrer Vorstellungen. Diskutieren Sie mit den DGS-Mitgliedern unserer Gruppe; vielleicht findet sich eine Lösung.
Vielleicht lassen Sie sich von der Idee Stereofotografie begeistern und treten der Deutschen Gesellschaft für Stereoskopie DGS bei. Hier geht’s zur Homepage